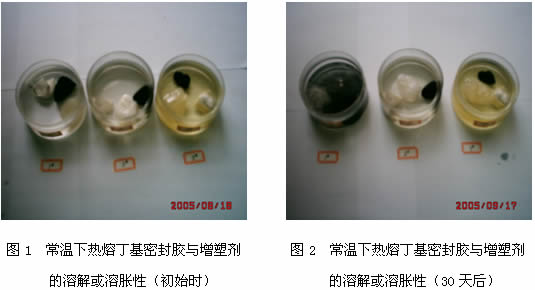

摘 要:本文通过对比实验,比较了掺油和未掺油
中空玻璃密封胶的
耐久性、热
老化性能、
粘接性能以及与
热熔丁基密封胶的
相容性,比较了其制造的
中空玻璃的耐紫外辐照性能。深入分析了掺油
中空玻璃
密封胶所带来的一系列严重的质量问题及其在使用过程中的危害性。
Abstract: Through contrast test, characters of IG sealant filled by mineral oil were compared with those of the sealant unfilled by mineral oil ,such as durability ,heat aging resistance ,adhesive ability and the compatibility with hot melt butyl sealant ,and the ultraviolet irradiating resistance of the IG made by them . Sequences of serious quality problems caused by the use of the sealant filled by mineral oil and the Harmfullness in using were analysed.
关键词:中空玻璃
密封胶;矿物油;对比实验;性能
Keywords:IG sealant;Mineral Oil;Compared test;Character
1,前言
随着中央提出的建设节约型社会要求的逐步落实,
建筑节能具有特别重要的意义。今年7月1日,国家强制性标准GB50189《
公共建筑节能设计标准》正式颁布实施,标准对
建筑能耗作出了严格的限定,与未采取节能措施前相比,建筑的全年总能耗降低了50%。与此相呼应,北京、天津、上海、大连等地也陆续出台了相应的地方
建筑节能设计标准,标准规定了要达到的节能目标,同时强调市区建筑外
窗玻璃应该或必须采用中空玻璃。我国中空
玻璃行业步入了快速发展阶段。
作为中空玻璃重要
配套材料的中空玻璃密封胶同样面临着重大的发展机遇,但同时也面临着巨大的挑战。一方面,市场进入者显著增加,产品价格一路走低,市场竞争激烈;另一方面,原材料价格大幅上涨,企业的经营和生存经受了空前的压力和考验。于是,近年来,市场上出现了掺油的中空玻璃密封胶,由于其材料的价格相对低廉,并且可以提高胶的外观和
固化后胶层的亮度,因此许多厂家纷纷加以效仿,并以此作为产品的卖点向用户进行宣传和推广。但是,随着时间的推移,掺油的中空玻璃
密封胶带来的一系列严重的质量和性能问题逐渐显现,突出表现为:采用此类密封胶制作的中空玻璃使用寿命普遍较短,存在着大量漏水,漏气和出雾等现象,更为严重的是双道密封的中空玻璃(第二道密封胶为掺油密封胶)的第一道密封胶即热熔
丁基密封胶被软化
溶胀而流淌,从而影响了中空玻璃的正常使用。根据用户的投诉和反馈,经过多次现场调查和试验对比,本着对行业发展,用户负责的精神,我公司对此进行了专
门的研究。
2,对比实验
2.1,实验材料
中空玻璃热熔丁基密封胶,本公司产品;
甲基硅油,德国Wacker公司产品;酯类
增塑剂,德国Lanxess公司产品;矿物油,抚顺石油化工公司产品;1#中空玻璃密封胶,本公司产品;2#掺油中空玻璃密封胶,市售;3#掺油中空玻璃密封胶,市售。
2.2,实验仪器
PL3002电子天平,梅特勒-托利多仪器(上海)有限公司;CMT4304电子拉力机,深圳新三思材料检测有限公司;302A调温调湿箱,上海市试验仪器总厂;DHP-600电热恒温培养箱,黄石市医疗器械厂;中空玻璃紫外线辐照箱,秦皇岛玻璃研究院;TGA热重分析仪,Netzsch TG209。
2.3,性能测试
中空玻璃耐紫外线辐照性能:按照GB/T11944《中空玻璃》进行。
粘结性能:按照GB/T13477《
建筑密封材料试验方法》进行,H型试样。
热老化性能:按照GB16776《建筑用
硅酮结构密封胶》进行。
耐久性能:按照GB16776《建筑用
硅酮结构密封胶》进行。
热重分析:升温速率为 10K / min。
3,结果与讨论
3.1,掺油的中空玻璃密封胶与中空玻璃热熔丁基密封胶的相容性
在讨论二者的相容性之前,先通过实验观察中空玻璃密封胶常用的
增塑剂与热熔丁基密封胶的溶解或溶胀性,实验结果见表1,图1,图2。
表1 常温下热熔丁基密封胶与增塑剂的溶解或溶胀性
时间,天
|
初始时
|
天
|
天
|
天
|
矿物油
|
无变化
|
变软,表面溶胀
|
溶解发粘
|
丁基胶溶解
|
甲基硅油
|
无变化
|
无变化
|
无变化
|
无变化
|
酯类增塑剂
|
无变化
|
无变化
|
无变化
|
无变化
|
注:图1,图2自左至右增塑剂分别为1#-矿物油,2#-甲基硅油,3#-酯类增塑剂。
上一页123下一页